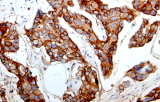
E-cadherina
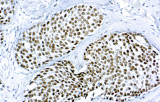
GATA3
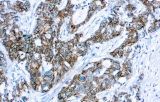
p120 Catenina

La patología ginecológica es la subespecialidad médica enfocada en el diagnóstico de enfermedades del tracto genital femenino, abarcando desde adenocarcinomas endocervicales hasta tumores de células germinales ováricos. Los cinco cánceres ginecológicos primarios son el cáncer de ovario, endometrio/útero, cérvix, vulva y vagina, cada uno con etiologías y factores de riesgo distintos, incluyendo edad, antecedentes familiares e influencias hormonales.
El cáncer de mama, aunque no es una malignidad ginecológica, es un cáncer frecuente en mujeres y plantea desafíos diagnósticos. Las características clínicas clave incluyen masas palpables, cambios en el pezón y alteraciones cutáneas. La evaluación patológica precisa es crítica para la clasificación y planificación del tratamiento.
Importancia de los anticuerpos primarios diagnósticos en IHQ
La inmunohistoquímica (IHQ) con anticuerpos primarios CE/IVD es esencial para el diagnóstico y clasificación precisos de malignidades ginecológicas y mamarias. Estos anticuerpos permiten la detección precisa de marcadores tumorales y proteínas celulares, apoyando el diagnóstico diferencial y guiando estrategias de tratamiento personalizadas.
Cánceres ginecológicos
Estudios recientes destacan el valor diagnóstico de las proteínas del complejo SWI/SNF, particularmente ARID1B, para identificar malignidades ginecológicas desdiferenciadas e indiferenciadas, tumores agresivos con mal pronóstico. La IHQ de ARID1B ofrece alta especificidad y se incorpora cada vez más en paneles diagnósticos para mejorar la precisión. Paneles con marcadores adicionales también ayudan a diferenciar sarcomas uterinos, aumentando la exactitud diagnóstica. Evidencia emergente sugiere que ARID1B podría representar un objetivo terapéutico potencial en carcinoma ovárico de células claras, aunque las aplicaciones clínicas siguen siendo investigativas.
Cáncer de mama
Los anticuerpos primarios contra receptor de estrógeno (ER), receptor de progesterona (PR), HER2 y Ki-67 siguen siendo la piedra angular de la clasificación y decisiones terapéuticas en cáncer de mama. Estos anticuerpos están validados clínicamente y marcados CE/IVD para garantizar detección confiable y reproducible de biomarcadores, crucial para guiar terapia hormonal y estrategias de tratamiento dirigido.
Ventajas de los anticuerpos primarios CE/IVD en IHQ diagnóstica
- Alta especificidad y sensibilidad: Permiten identificación confiable de subtipos tumorales y minimizan diagnósticos erróneos.
- Cumplimiento normativo (marcado CE/IVD): Asegura calidad, seguridad y aplicabilidad clínica.
- Protocolos validados y amplio uso clínico: Garantizan reproducibilidad entre laboratorios.
- Rol complementario con diagnóstico molecular: La integración con secuenciación y otros datos moleculares mejora la clasificación tumoral integral, como se ilustra en el manejo del carcinoma endometrial.